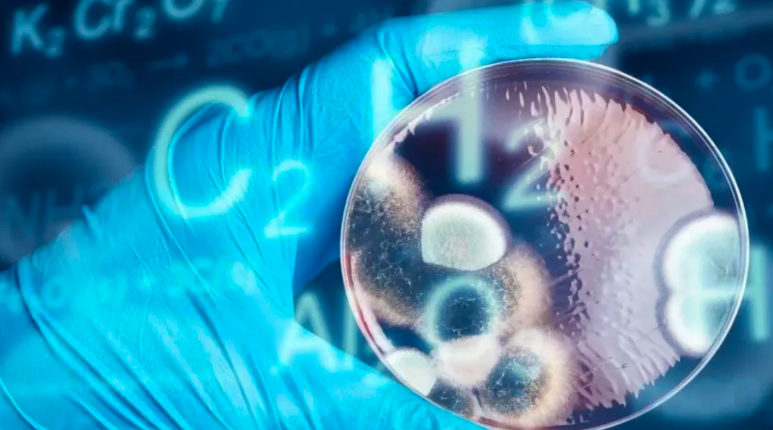

鄭州源創(chuàng)基因科技有限公司成立于2016年,由哥倫比亞大學(xué)博士后趙輝,歸國(guó)創(chuàng)辦的國(guó)家高新技術(shù)企業(yè)。擁有97項(xiàng)知識(shí)產(chǎn)權(quán)及實(shí)用技術(shù),業(yè)務(wù)遍布上海、重慶、深圳、北京等城市,總部在鄭州航空港區(qū)。
基于第七次人口普查數(shù)據(jù),當(dāng)前國(guó)內(nèi)65歲以上的老年群體約有1.9億人,占到總?cè)丝诘?/span>13.5%,而人口老齡化程度的世界平均水平僅為9.3%。
隨著工業(yè)化、城鎮(zhèn)化、人口老齡化進(jìn)程加快,中國(guó)居民生產(chǎn)生活方式和疾病譜不斷發(fā)生變化。心腦血管疾病、癌癥、慢性呼吸系統(tǒng)疾病、糖尿病等慢性非傳染性疾病導(dǎo)致的死亡人數(shù)占總死亡人數(shù)的88%,導(dǎo)致的疾病負(fù)擔(dān)占疾病總負(fù)擔(dān)的70%以上。

慢性病是慢性非傳染性疾病(NCDs)的簡(jiǎn)稱,諸如常見的高血壓、惡性腫瘤、糖尿病、血脂紊亂、甲亢/甲減、骨質(zhì)疏松冠心病、腦卒中、心包炎、老年癡呆等,慢性呼吸系統(tǒng)疾病均具有知曉率低、可控性差、病程漫長(zhǎng)、發(fā)病率高的特點(diǎn)。
幸運(yùn)的是,近年來(lái)對(duì)干細(xì)胞技術(shù)研究的逐步深入,人們對(duì)其應(yīng)用領(lǐng)域和預(yù)期療效也越發(fā)了解。
干細(xì)胞被主流醫(yī)學(xué)界視為“生命之源”“萬(wàn)能細(xì)胞”,其原因在于干細(xì)胞所具備的種種“再生”特性——它不僅具有自我復(fù)制能力(self-renewing),而且還可以根據(jù)特定誘導(dǎo)條件而分化為各類功能細(xì)胞,在奇特的歸巢效應(yīng)(homing)指引下,干細(xì)胞搭乘外周血的“便車”尋找到適宜的干細(xì)胞巢,在其中安居樂(lè)業(yè)。

下面,我們列舉了幾例可被干細(xì)胞療法改善的慢性病,一起看看吧!
01帕金森病
神經(jīng)系統(tǒng)疾病是全球第二大死因,也是醫(yī)學(xué)界面臨的主要挑戰(zhàn)之一,而帕金森病(Parkinson's disease)正是其中的典型代表。國(guó)內(nèi)的一項(xiàng)臨床研究納入了26例帕金森病患者,經(jīng)導(dǎo)管將間充質(zhì)干細(xì)胞移植到大腦后動(dòng)脈及小腦上動(dòng)脈。結(jié)果發(fā)現(xiàn),移植后患者疾病評(píng)分明顯下降,對(duì)肝腎功能無(wú)不良影響,也無(wú)發(fā)熱等不良反應(yīng)。這項(xiàng)臨床研究肯定了間充質(zhì)干細(xì)胞的作用,說(shuō)明其治療帕金森病可明顯改善患者的日常活動(dòng)和運(yùn)動(dòng)功能。

此外,神經(jīng)干細(xì)胞NSCs可產(chǎn)生神經(jīng)營(yíng)養(yǎng)因子,促進(jìn)神經(jīng)再生及血管新生,調(diào)控微環(huán)境的炎癥反應(yīng),降低腦內(nèi)促炎因子、腫瘤壞死因子-α、白細(xì)胞介素-1β水平。不僅如此,NSCs還可治療多種神經(jīng)系統(tǒng)損傷疾病/退行性疾病,例如腦缺血損傷、腦出血、脊髓損傷、多發(fā)性硬化癥,避免患者致殘致死。
02糖尿病
2006年,Novocell公司(現(xiàn)名Viacyte)的研究團(tuán)隊(duì)在Nature Biotechnology上發(fā)表論文,描述了將人類胚胎干細(xì)胞分化成為能夠分泌胰島素、胰高血素等多種激素的內(nèi)分泌胰島細(xì)胞的過(guò)程。

在2008年,這一團(tuán)隊(duì)通過(guò)將人類胚胎干細(xì)胞分化的胰島內(nèi)胚層移植到小鼠體內(nèi),成功在動(dòng)物體內(nèi)分化出對(duì)葡萄糖敏感的內(nèi)分泌細(xì)胞,并且證明這些細(xì)胞能夠幫助小鼠抵抗高血糖。
研究發(fā)現(xiàn),間充質(zhì)干細(xì)胞對(duì)于改善糖尿病患者胰島功能和肝臟糖脂代謝有顯著功效,同時(shí)起到了降糖的作用。
干細(xì)胞治療2型糖尿病的第一個(gè)臨床研究就是關(guān)于間充質(zhì)干細(xì)胞的,研究者將胰內(nèi)間充質(zhì)干細(xì)胞輸注與高壓氧治療相結(jié)合,在試驗(yàn)的一年隨訪中觀察到患者的代謝參數(shù)得到明顯改善,并且對(duì)于胰島素的需求量也大大降低。

臨床試驗(yàn)發(fā)現(xiàn),25例2型糖尿病患者自體干細(xì)胞移植治療一年后,糖尿病患者血糖含量得到有效控制,胰島β細(xì)胞功能得到改善、胰島素需求量減少。
越來(lái)越多的研究表明,干細(xì)胞在糖尿病并發(fā)癥的治療中也起著重要作用。
03心血管疾病
心血管疾病(Cardiovascular disease,CVD)危害極大,目前的藥物治療和心血管介入干預(yù)手段難以對(duì)已經(jīng)發(fā)生壞死的心肌進(jìn)行修復(fù)再生。
研究者通過(guò)阿霉素(DOX)處理大鼠心肌細(xì)胞建立體外心肌損傷模型,通過(guò)來(lái)源于人臍帶間充質(zhì)干細(xì)胞的外泌體干預(yù)后,發(fā)現(xiàn)細(xì)胞內(nèi)炎癥因子TNF-α和IL-6的水平顯著下降,并且外泌體還能恢復(fù)線粒體的呼吸作用,維持其形態(tài),使心肌細(xì)胞免受DOX的誘導(dǎo)毒性損傷。這提示人們可用干細(xì)胞治療心肌損傷。
04自身免疫性皮膚病
自身免疫性皮膚病是自身免疫疾病的一種,由于發(fā)病部位顯著,給患者造成了沉重的心理壓力和社交障礙。
以白癜風(fēng)為例,其為黑色素細(xì)胞缺乏引發(fā)的色素脫失性皮膚黏膜疾病。有研究指出,窄譜中波紫外線(NB-UVB)聯(lián)合間充質(zhì)干細(xì)胞對(duì)白癜風(fēng)小鼠模型具有改善效果,與CD8+T細(xì)胞聯(lián)合培養(yǎng)的真皮MSCs可抑制前者增殖,且真皮MSCs輸注能使患者再色素化,激活蛋白激酶信號(hào)通路,減少過(guò)氧化氫造成的氧化應(yīng)激。
此外,MSCs還在特應(yīng)性皮炎(AD)、銀屑病、系統(tǒng)性紅斑狼瘡(SLE)、大皰性表皮松解癥(RDEB)等疾病的治療中體現(xiàn)出較大潛力。

除了以上詳細(xì)列舉的慢性疾病之外,有研究表明,間充質(zhì)干細(xì)胞在肌肉骨骼疾病、阿爾茨海默病、肝病、神經(jīng)退行性疾病等常見慢性疾病的臨床進(jìn)展中均取得很好的進(jìn)展。相信隨著越來(lái)越多的臨床研究的開展,可以暢想,未來(lái)慢性病患者很可能藉由干細(xì)胞技術(shù)得到新的治療策略。
圖片:來(lái)源于網(wǎng)絡(luò)
【免責(zé)聲明】圖片來(lái)源于網(wǎng)絡(luò),旨在分享相關(guān)知識(shí),僅作信息交流之目的,如涉及版權(quán)等問(wèn)題,請(qǐng)聯(lián)系我們及時(shí)處理。文章內(nèi)容不作為相關(guān)醫(yī)療指導(dǎo)或用藥建議,僅供參考。






